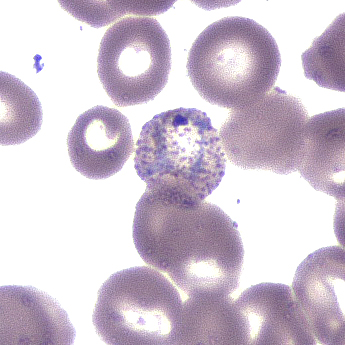
Case392_C.jpg

Case #392 – March 2015
A 39-year-old male, originally from Fiji, presented to a hospital in Pohnpei, Federated States of Micronesia (FSM) with fever, chills, and head and body aches. Blood work-up revealed a normal platelet count, but a low WBC count and raised ALT and creatine. Serologic testing for leptospirosis was negative. It was later learned that approximately five days before arriving in the FSM, the patient had spent nearly a month in the Solomon Islands. Smears were then made from blood collected in EDTA and stained with a rapid stain and examined microscopically. Images were captured and sent to the DPDx Team for diagnostic assistance. Figures A-D show four of the images. What is your diagnosis? Based on what criteria?

Figure A

Figure B
Figure C

Figure D
This case and images were kindly provided by the FSM Department of Health and Social Affairs, Pohnpei, FSM.
Images presented in the monthly case studies are from specimens submitted for diagnosis or archiving. On rare occasions, clinical histories given may be partly fictitious.
DPDx is an educational resource designed for health professionals and laboratory scientists. For an overview including prevention, control, and treatment visit www.cdc.gov/parasites/.